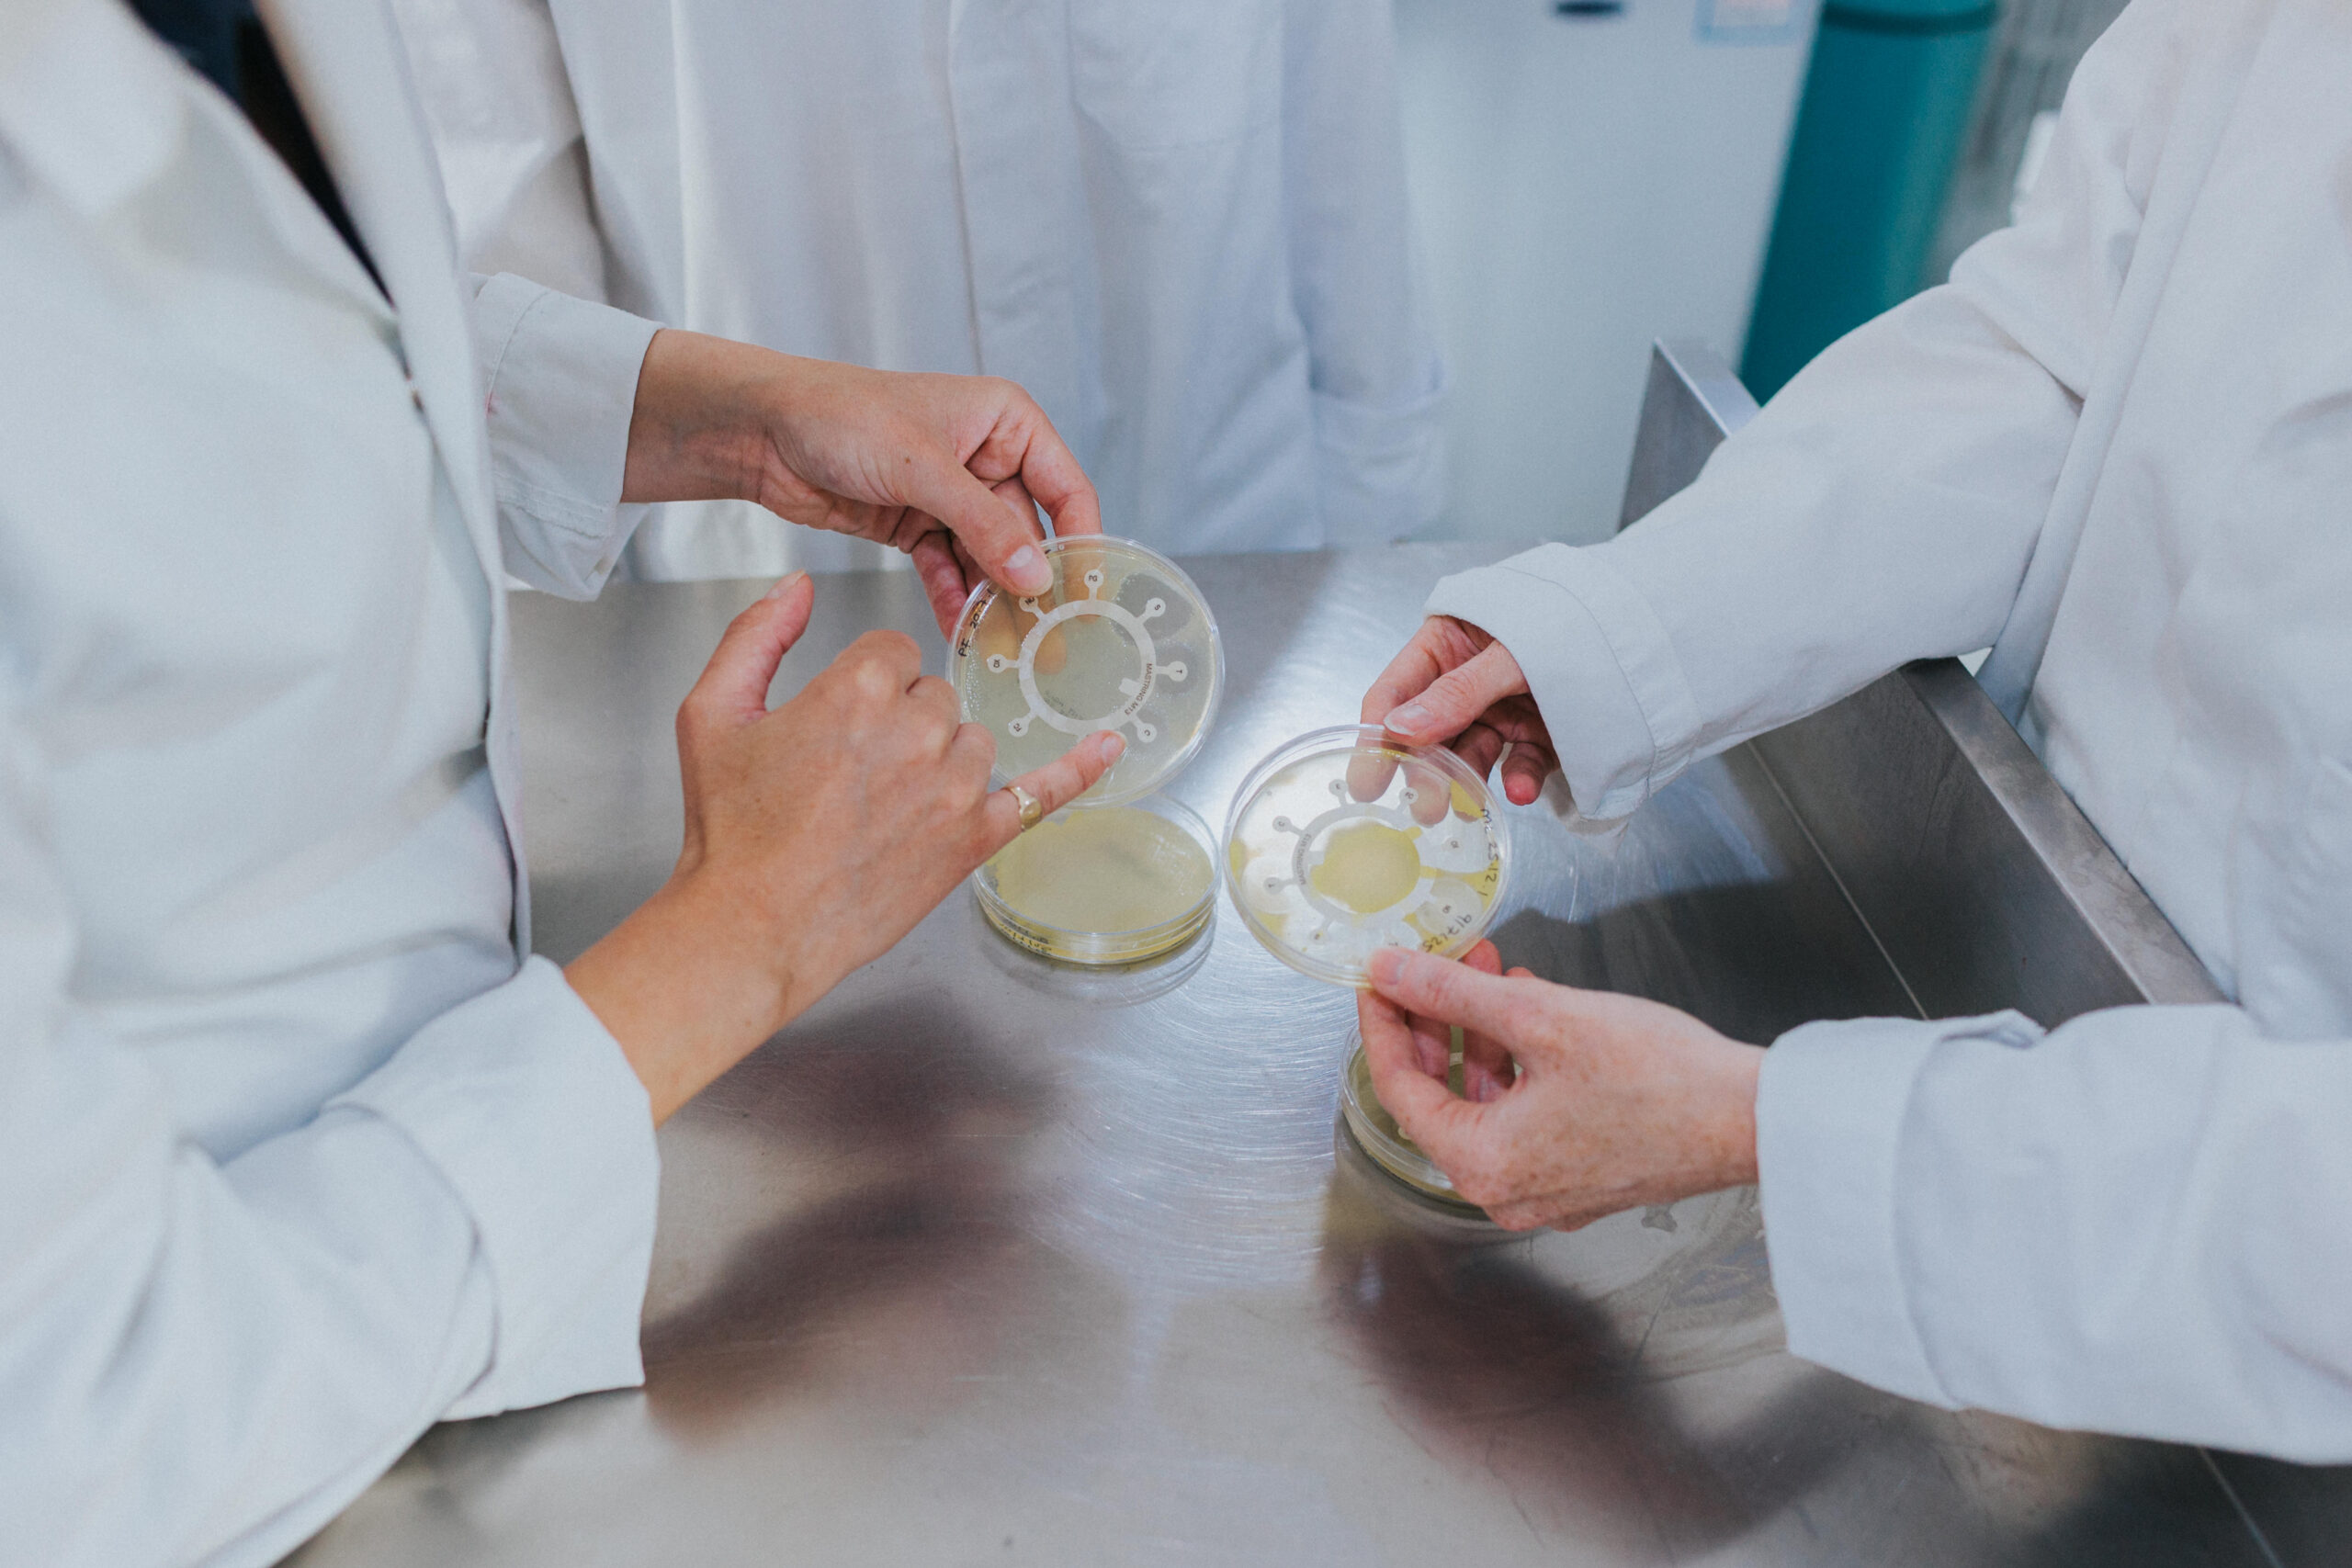

Shropshire Brand Photographer | Commercial Photography & Video

Science has never looked so good.

The Brief
Darwin Biological are a biological supplies company, the kind of team that makes you realise how much quiet, skilled work goes on behind the scenes of things most of us take for granted. Their brief was clear: headshots for around six team members, a full library of lab and office imagery, and short video clips for the website and social media. They wanted to look professional and credible. But they also wanted to look human.
Both things at once. My favourite kind of job.

On Set
There is something genuinely fascinating about being handed a camera and let loose in a working lab. The day covered, *deep breath* packing boxes, pouring algae, sexing drosophila, microbiology, locusts, organ dissection, bacteria slopes, fly media, and at least one very important cup of tea.
Not your average Tuesday.
But underneath all of that, what I was really photographing was a team who clearly love what they do. People who are brilliant at something niche and complex and vital, and who wanted the world to see that without losing the warmth and personality that makes them them.
Lab coats. Lots of smiles. Laughing over tea. The kind of images that say: we know our stuff, and we’re also really good to work with.
That’s the brief I love most.

Photo & Video
As well as the full still photography library, we shot short clips specifically built for web and social — algae swirling, bacteria slopes being created, flies being sexed (yes, really), phones being answered, media being poured. The kind of content that brings a website to life and gives social media something genuinely interesting to stop the scroll.

Find Darwin Biological
If you work in education or research and want to know more about what Darwin Biological offer, you can find them here:
- Website — www.darwinbiological.co.uk
- Instagram — @darwin_bio
- Facebook — @darwinbiological
- LinkedIn — @darwin-bio
Need Brand Photography for Your Business?
Whether you’re a team of three in a studio or a lab full of scientists doing things I’ll need Googling afterwards, I’d love to help you show the world what you actually do.
Good brand photography isn’t about looking bigger than you are. It’s about looking exactly like you are, just seen properly.
→ Get in touch to chat about your shoot
Locusts, algae, and excellent tea. Some days this job is really something. 🔬
Comments